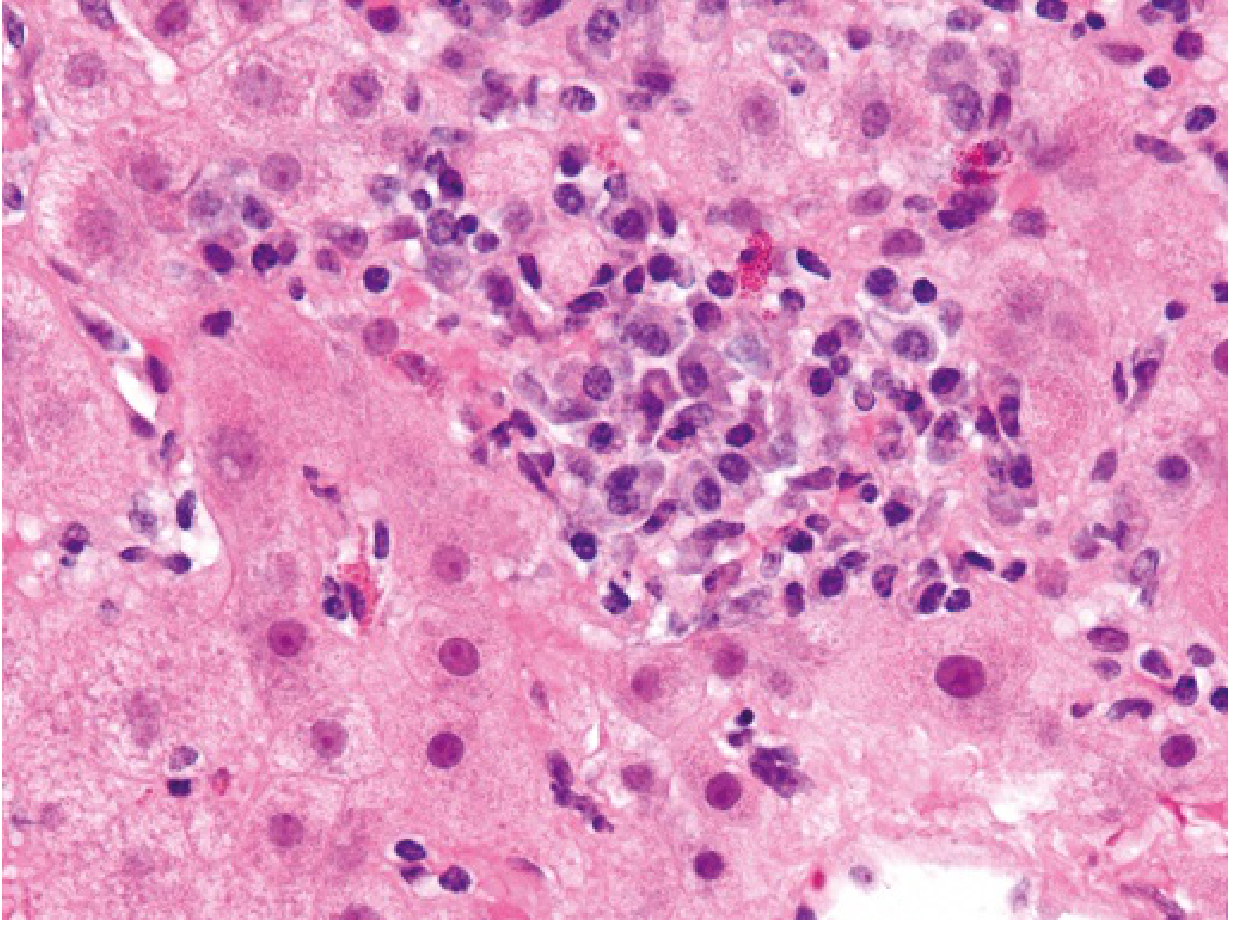

make a 3 page report on imflammatory diseases of the liver
Reading File
Finding Sources
Finding Sources
Finding Sources
Finding Sources
Reading File
Reading File
Reading File
Searching Images
hepatitis liver inflammation pathology histology
Reading File
Reading File
Loading Image
Loading Image
Reading File
Reading File
Loading Image
I now have comprehensive content from authoritative textbooks. Let me compile the full 3-page report.
Inflammatory Diseases of the Liver
Introduction
The liver, as the body's principal metabolic and detoxifying organ, is uniquely susceptible to inflammatory injury from a wide range of insults — infectious, immunological, toxic, and metabolic. Collectively termed hepatitis (Greek: hepar = liver, itis = inflammation), these conditions range from acute self-limited episodes to chronic progressive disease culminating in cirrhosis and hepatocellular carcinoma (HCC). Chronic necroinflammation of the liver — defined as persistent hepatic injury lasting more than six months — affects hundreds of millions of people worldwide and accounts for over one million deaths annually.
The major categories of inflammatory liver disease include:
- Viral hepatitis (hepatitis A, B, C, D, E)
- Autoimmune hepatitis (AIH)
- Alcoholic hepatitis / alcohol-associated liver disease
- Primary biliary cholangitis (PBC)
- Primary sclerosing cholangitis (PSC)
- Drug-induced liver injury (DILI)
Page 1 — Viral Hepatitis
Overview
Viral hepatitis is the most common cause of hepatic inflammation globally. Five hepatotropic viruses — HAV, HBV, HCV, HDV, and HEV — account for the vast majority of cases. Nearly 300 million individuals are chronically infected with hepatitis B virus (HBV) and approximately 60 million with hepatitis C virus (HCV), making them the leading causes of cirrhosis and HCC worldwide. Non-hepatotropic viruses such as Epstein-Barr virus (EBV) and cytomegalovirus (CMV) can produce a hepatitis-like picture as well.
— Goldman-Cecil Medicine, p. 1573 | Robbins & Kumar Basic Pathology, p. 604
Hepatitis A Virus (HAV)
HAV is a nonenveloped, positive-strand RNA picornavirus transmitted via the fecal-oral route — through contaminated water, food, and person-to-person contact. The incubation period is 2–6 weeks. HAV infection is typically benign and self-limited; it does not establish a chronic carrier state and rarely (in ~0.1% of cases) causes fulminant hepatitis.
The cellular immune response — particularly cytotoxic CD8+ T cells — drives hepatocellular injury. IgM anti-HAV appears at symptom onset and is the primary diagnostic marker of acute infection. Lifelong immunity follows recovery. A highly effective vaccine has been available since 1995, reducing US cases by >95%.
— Robbins & Kumar Basic Pathology, p. 604
Hepatitis B Virus (HBV)
HBV is a partially double-stranded DNA virus (Hepadnaviridae). Outcomes range from:
- Acute hepatitis with viral clearance
- Nonprogressive chronic hepatitis
- Progressive chronic hepatitis → cirrhosis
- Fulminant hepatic failure
- Asymptomatic carrier state
Approximately 5–10% of immunocompetent adults who acquire HBV develop chronic infection. Perinatal transmission carries a much higher chronicity rate (~90%). The HBV surface antigen (HBsAg) is the primary screening marker; confirmatory testing uses HBV DNA quantification.
Chronic HBV can be treated — though not cured — with pegylated interferon-alpha (48 weeks) or lifelong oral nucleos(t)ide analogues: entecavir, tenofovir disoproxil fumarate (TDF), or tenofovir alafenamide (TAF). Treatment prevents fibrosis progression, cirrhosis decompensation, and HCC development.
Superinfection by hepatitis D virus (HDV), a defective RNA virus requiring HBsAg for replication, worsens outcomes and can precipitate acute decompensation even in a previously stable patient.
— Goldman-Cecil Medicine, p. 1574–1576
Hepatitis C Virus (HCV)
HCV is a positive-sense RNA flavivirus transmitted primarily through blood-to-blood contact (intravenous drug use, transfusions prior to 1992, needlestick injuries). Approximately 75–85% of acutely infected individuals develop chronic infection. HCV is the leading indication for liver transplantation in many countries.
A pivotal advance is the development of direct-acting antiviral (DAA) drugs — pan-genotypic oral regimens (e.g., sofosbuvir/velpatasvir, glecaprevir/pibrentasvir) that cure >95% of patients and prevent the hepatic and extrahepatic complications of HCV. Screening with anti-HCV antibody followed by confirmatory HCV RNA testing is standard.
Clinical Features and Histology of Viral Hepatitis
Clinical symptoms of both acute and chronic viral hepatitis are frequently nonspecific. Patients may present with fatigue, right upper quadrant discomfort, anorexia, nausea, and jaundice — or remain asymptomatic with abnormal liver enzymes found incidentally.
Laboratory findings:
- ALT and AST elevated 2–25× upper limit of normal
- ALT typically higher than AST (in contrast to alcoholic hepatitis)
- Bilirubin, albumin, and prothrombin time normal unless advanced disease
Histologically, acute viral hepatitis demonstrates:
- Portal area mononuclear infiltrates (predominantly T lymphocytes and plasma cells)
- Interface hepatitis with lobular disarray
- Hepatocyte ballooning degeneration and apoptotic (Councilman) bodies
- Focal hepatocellular necrosis
Chronic hepatitis adds periportal fibrosis, bridging fibrosis, and ultimately cirrhosis.

Acute viral hepatitis (hepatitis B): dense portal and lobular inflammatory infiltrate with hepatocyte injury on H&E biopsy.
— Robbins & Kumar Basic Pathology, p. 604–605 | Goldman-Cecil Medicine, p. 1574
Page 2 — Autoimmune and Alcohol-Associated Hepatitis
Autoimmune Hepatitis (AIH)
Autoimmune hepatitis is a chronic, progressive inflammatory disease of the liver driven by a loss of immune tolerance to hepatocyte antigens. It has a strong female predominance (78%) and is associated with other autoimmune diseases (thyroiditis, rheumatoid arthritis, ulcerative colitis).
Classification
AIH is divided into two types based on autoantibody profiles:
| Feature | Type 1 AIH | Type 2 AIH |
|---|---|---|
| Predominant age | Adults | Children/adolescents |
| Key antibodies | ANA, anti-smooth muscle (ASMA), anti-SLA/LP | Anti-LKM-1, anti-LC1, anti-SLA/LP |
| ASMA positivity | ~65% | Negative |
Anti-SLA/LP antibodies (present in 25–35% of type 1 and also type 2) are highly specific for AIH.
A small subset of patients exhibits overlap syndrome — features of AIH combined with primary biliary cholangitis or primary sclerosing cholangitis.
Histopathology
Histologically, AIH shares features with chronic viral hepatitis but with characteristic additions:
- Interface hepatitis — mononuclear cell infiltration at the portal-parenchymal interface
- Plasma cell predominance in inflammatory infiltrates (a key distinguishing feature)
- Hepatocyte rosettes — regenerating hepatocytes arranged around a dilated canaliculus
- Confluent or bridging necrosis in severe cases
Autoimmune hepatitis: focal lobular hepatitis with a dense infiltrate of plasma cells — the hallmark histological feature.
— Robbins & Kumar Basic Pathology, p. 607
Diagnosis
The International Autoimmune Hepatitis Group (IAIHG) scoring system incorporates serology, histology, exclusion of viral and drug causes, and response to therapy. Elevated serum immunoglobulins (especially IgG) are characteristic. Liver biopsy remains essential for confirmation in non-viral chronic hepatitis.
Treatment and Prognosis
Immunosuppression with prednisolone ± azathioprine induces remission in ~90% of patients, including those with cirrhosis at diagnosis. End-stage disease warrants liver transplantation; the 10-year post-transplant survival is 75%, though recurrence occurs in 20% of transplanted livers.
Up to 30% of adult-onset AIH patients already have cirrhosis at diagnosis, underscoring the importance of early detection.
— Robbins & Kumar Basic Pathology, p. 607 | Goldman-Cecil Medicine, p. 1574–1576
Alcoholic Hepatitis / Alcohol-Associated Liver Disease (ALD)
Alcohol-associated liver disease represents a spectrum of injury:
Steatosis (fatty liver) → Steatohepatitis → Fibrosis → Cirrhosis → HCC
Approximately 8–20% of patients with steatosis will ultimately progress to cirrhosis. The risk for HCC in decompensated alcoholic cirrhosis approaches 1% per year. Steatosis is reversible within two weeks of alcohol cessation.
Pathophysiology
Ethanol metabolism generates excess NADH, disrupting fatty acid oxidation and promoting hepatic fat accumulation. Acetaldehyde — a toxic ethanol metabolite — causes direct hepatocellular damage, mitochondrial dysfunction, and impairs protein export. Alcohol also promotes gut barrier dysfunction and endotoxemia, activating Kupffer cells (hepatic macrophages) via TLR4 signaling to release TNF-α, IL-1β, and IL-6, sustaining the inflammatory cascade.
Clinical Presentation and Laboratory Findings
Alcoholic hepatitis presents with fever, jaundice, right upper quadrant pain, and tender hepatomegaly — often in the setting of recent heavy alcohol intake. Peripheral leukocytosis is common. A key diagnostic clue is the AST:ALT ratio >2:1 (rarely exceeding 300 IU/L in either), in contrast to viral hepatitis where ALT predominates. Additional findings include:
- Hypoglycemia (impaired gluconeogenesis, depleted glycogen stores)
- Elevated GGT and alkaline phosphatase
- Coagulopathy (prolonged PT/INR) in severe disease
- Thrombocytopenia
Histopathology
On liver biopsy, alcoholic steatohepatitis shows:
- Macrovesicular steatosis (large fat vacuoles displacing hepatocyte nuclei)
- Hepatocyte ballooning degeneration
- Mallory-Denk bodies (tangled intermediate filaments — a cytoplasmic inclusion)
- Neutrophilic lobular inflammation
- Early perisinusoidal fibrosis ("chicken-wire" pattern)

Alcoholic steatohepatitis: prominent macrovesicular steatosis (white vacuoles), hepatocyte injury, and mixed inflammatory infiltrate on H&E biopsy.
— Rosen's Emergency Medicine, p. 1477–1479 | Robbins & Kumar Basic Pathology
Severity Scoring and Management
Maddrey's Discriminant Function (MDF) is the most widely used severity score:
MDF = 4.6 × (PT − control PT) + serum bilirubin (mg/dL)
- MDF ≥ 32 indicates severe alcoholic hepatitis with significant short-term mortality and is an indication for treatment
- Patients with MDF ≥ 32 should receive prednisolone 40 mg/day PO or methylprednisolone 32 mg/day IV for 28 days
- Alcohol cessation is the single most important intervention
- Nutritional support is essential (protein-calorie malnutrition is near-universal in severe AH)
- Pentoxifylline was previously used but evidence is now limited vs. corticosteroids
— Rosen's Emergency Medicine, p. 1479
Page 3 — Cholestatic and Drug-Induced Inflammatory Liver Disease, Diagnosis, and Management
Primary Biliary Cholangitis (PBC)
Primary biliary cholangitis (formerly "primary biliary cirrhosis") is a chronic autoimmune cholestatic liver disease characterized by the progressive destruction of intrahepatic bile ducts, leading to chronic cholestasis, fibrosis, and cirrhosis.
Epidemiology and Pathogenesis
PBC predominantly affects middle-aged women (female:male ratio ~9:1). Its pathogenesis involves loss of immune tolerance to mitochondrial antigens — specifically the E2 subunit of pyruvate dehydrogenase complex (PDC-E2) — expressed on biliary epithelial cells. Autoreactive CD4+ and CD8+ T cells infiltrate and destroy small intrahepatic bile ducts.
Clinical Features
- Insidious onset; many patients are asymptomatic at diagnosis
- Pruritus — often the earliest and most distressing symptom
- Fatigue
- Xanthomas and xanthelasmas (from chronic hypercholesterolemia)
- Progressive jaundice in later stages
- Associated autoimmune conditions: Sjögren syndrome, CREST, hypothyroidism
Diagnosis
- Anti-mitochondrial antibodies (AMA) — present in >95% of patients; highly specific
- Elevated alkaline phosphatase and GGT (cholestatic pattern)
- Elevated IgM
- Liver biopsy (if needed): florid duct lesion — granulomatous destruction of bile ducts with lymphocytic infiltration
Treatment
- Ursodeoxycholic acid (UDCA) 13–15 mg/kg/day — first-line; slows progression in most patients
- Obeticholic acid (OCA) — second-line for inadequate UDCA response
- Cholestyramine for pruritus; rifampicin and naltrexone for refractory pruritus
- Liver transplantation for end-stage disease
— Yamada's Textbook of Gastroenterology | Schwartz's Principles of Surgery
Primary Sclerosing Cholangitis (PSC)
PSC is a chronic progressive inflammatory and fibrosing disease of both intra- and extrahepatic bile ducts, leading to biliary strictures, chronic cholestasis, and eventual cirrhosis. Unlike PBC, PSC predominantly affects young men and has no curative medical therapy.
Associations
A critical feature is the strong association with inflammatory bowel disease (IBD) — approximately 70% of PSC patients have concurrent IBD, most commonly ulcerative colitis.
Clinical Features and Diagnosis
- Asymptomatic elevation of ALP and GGT (often the initial presentation)
- Intermittent biliary obstruction: jaundice, pruritus, right upper quadrant pain
- Recurrent episodes of bacterial cholangitis (fever, rigors)
- MRCP (magnetic resonance cholangiopancreatography) is the imaging modality of choice: multifocal strictures and beading of bile ducts
- pANCA positive in ~80%; AMA typically negative (distinguishing from PBC)
- Significantly elevated risk of cholangiocarcinoma (~10–20% lifetime risk)
Management
- UDCA — used but has not clearly demonstrated survival benefit in PSC
- Endoscopic dilation/stenting for dominant strictures
- Liver transplantation is the only definitive treatment for end-stage PSC; however, disease recurs in ~20% of grafts
- Annual surveillance with MRCP and CA 19-9 for cholangiocarcinoma
— Murray & Nadel's Textbook of Respiratory Medicine | Sleisenger and Fordtran's Gastrointestinal and Liver Disease
Drug-Induced Liver Injury (DILI)
As the principal site of drug metabolism, the liver is vulnerable to injury from a vast array of therapeutic and environmental agents. DILI may manifest as hepatocellular, cholestatic, or mixed patterns of injury.
Mechanisms
| Type | Mechanism | Example |
|---|---|---|
| Intrinsic (predictable) | Direct toxicity; dose-dependent | Acetaminophen overdose |
| Idiosyncratic (unpredictable) | Immune-mediated or aberrant metabolism; host-dependent | Isoniazid, halothane, amoxicillin-clavulanate |
Acetaminophen is the most common cause of acute liver failure requiring transplantation in the United States. The toxic metabolite NAPQI (N-acetyl-p-benzoquinone imine) accumulates when glutathione stores are depleted, causing centrilobular necrosis.
Immune-mediated DILI occurs when a drug or its metabolite acts as a hapten — binding hepatocellular proteins to form neoantigens that trigger T cell responses. This pattern mimics autoimmune or viral hepatitis on biopsy.
Diagnosis
DILI is a diagnosis of exclusion, requiring:
- Temporal association with drug exposure
- Recovery after drug withdrawal (dechallenge)
- Exclusion of viral, autoimmune, and metabolic causes
- Recurrence upon re-exposure (rechallenge) — though ethically rarely performed
— Robbins & Kumar Basic Pathology, p. 607–608
Summary Comparison of Inflammatory Liver Diseases
| Disease | Key Marker | Pattern | First-Line Treatment |
|---|---|---|---|
| Hepatitis A | IgM anti-HAV | Acute, self-limited | Supportive |
| Hepatitis B (chronic) | HBsAg, HBV DNA | Hepatocellular | Entecavir / TDF / TAF |
| Hepatitis C (chronic) | Anti-HCV, HCV RNA | Hepatocellular | DAA (sofosbuvir-based) |
| Autoimmune Hepatitis | ANA, ASMA, elevated IgG | Hepatocellular | Prednisolone ± azathioprine |
| Alcoholic Hepatitis | AST:ALT >2:1, MDF score | Steatohepatitis | Alcohol cessation; prednisolone (MDF ≥32) |
| Primary Biliary Cholangitis | AMA (anti-M2), elevated ALP | Cholestatic | Ursodeoxycholic acid |
| Primary Sclerosing Cholangitis | pANCA, MRCP strictures | Cholestatic | Endoscopy; transplant |
| Drug-Induced Liver Injury | Temporal drug exposure | Variable | Drug withdrawal |
Complications and Progression
All forms of chronic hepatic inflammation share common downstream consequences if inadequately controlled:
- Hepatic fibrosis — driven by activated hepatic stellate cells producing excess collagen
- Cirrhosis — irreversible architectural distortion with regenerative nodules; the common endpoint of all chronic inflammatory liver disease
- Portal hypertension — leading to esophageal varices, ascites, hepatorenal syndrome, and spontaneous bacterial peritonitis (SBP)
- Hepatic encephalopathy — ammonia accumulation impairing cerebral metabolism
- Hepatocellular carcinoma — increased risk with HBV, HCV, alcoholic cirrhosis, and NASH-related cirrhosis
Liver transplantation remains the definitive treatment for end-stage inflammatory liver disease of any etiology, though recurrence of the primary disease in the graft is a recognized concern in autoimmune hepatitis (~20%), PSC (~20%), and PBC.
— Goldman-Cecil Medicine, p. 1573–1576 | Rosen's Emergency Medicine, p. 1479 | Robbins & Kumar Basic Pathology, p. 607–608
Sources: Goldman-Cecil Medicine International Edition (Elsevier, 2022) | Robbins & Kumar Basic Pathology, 11e (Elsevier, 2023) | Robbins, Cotran & Kumar Pathologic Basis of Disease, 10e | Rosen's Emergency Medicine, 9e | Sleisenger and Fordtran's Gastrointestinal and Liver Disease | Yamada's Textbook of Gastroenterology, 7e | Murray & Nadel's Textbook of Respiratory Medicine | Schwartz's Principles of Surgery, 11e
This is a shared conversation. Sign in to Orris to start your own chat.